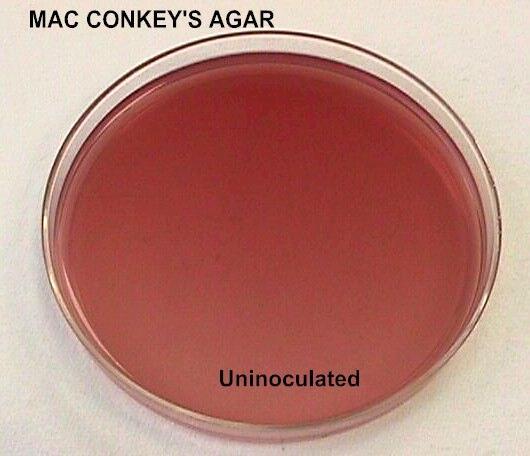

What is the selective agent in MacConkey agar?
Bile salts and cystal violet
These objects inhibit the growth of gram positive bacteria
What is the Phenylalanine slant used for?

This media is used to identify a bacteria’s ability to remove the amine group NH2 from the amino acid phenylalanine. This is shown by the production of pyruvic acid
What do Lysine/ornithine decarboxylase broths contain?
What colors can the phenol red broths change to, and what does each color represent?
NOTE: It is best to read tubes between 18-24 Hours

What do citrate slants contain?
Citrate slants contains ammonium phosphate as a source of nitrogen and sodium citrate as a carbon source.
How are results read on TSI Slants?

What is Eosin Methylene blue Agar (EMB Agar) used for?

Eosin Methylene blue agar is a complex, selective, and differential medium used to inhibit the groth of gram positive organisms and to
identify lactose fermenters
What is MacConkey agar used for?
It is used to isolate and differentiate gram negative organisms based on the ability to ferment lactose
What are TSI Slants used for?

TSI slants are used to differentiate bacteria on the basis of glucose, lactose, and sucrose fermentation, and sulfur reduction.
What does the phenylalanine slant contain?
The slant contains the amino acid phenylalanine, and organisms producing phenylalanine deaminase will deaminate the phenylalanine and this produces ammonia and phenyl pyruvic acid.
What are Phenol red broths used for?

These broths are used to determine if the bacteria ferment carbohydrates and if they produce gas while fermenting carboyhdrates or not.
What is the pH indicator for Lysine/ornithine decarboxylase broths?
Bromcresol purple
In regards to the Lysine/ornithine decarboxylase broths, describe the possible results of the media after innoculation
NOTE: Decarboxylation of lysine yeilds cadaverine; decarboxylation of orinthine yields putrescine.
NOTE: Inoculated tubes MUST be coved with a layer of sterile minieral oil to produce an anerobic condition.
What is the differential for MacConkey agar?
Lactose fermentation
What is a Urea Broth used for?

It is a differential & enzyme test used to differentiate rapid urease-positive bacteria from slower urease-positive and urease-negative bacteria.
Bacteria that produce the enzyme urease will break down the urea into ammonia and carbon dioxide giving the media an alkaline pH.
NOTE: This broth contains urea, peptone, potassium phosphate, glucose, and phenol red.
What are Lysine/ornithine decarboxylase broths used for?

Used to differentiate organisms in the family enterobacteriaceae and to ditinguishthem from other gram-negative rods.
After innoculating a decarboxylase test, what must you immediately do to the media?
Add a layer of mineral oil (10 drops) to create an anerobic environment for the tube.
What reagent is used in SIM tubes and what does it indicate?
Reagent used: Kovac’s reagent

What is SIM Medium tubes used for?

This medium is used for determination of three bacterial activities: Sulfur production, indole production from tryptophan, and motility (movement of bacteria) .
What is the differential for EMB Agar, and describe some changes seen in this agar.
Differential - Lactose
NOTE: E. Coli appears as blue-black colonies with a metallic green shine.
What are the selective agents in EMB Agar?
The selective agents are:
The dyes are inhibit the growth of Gram + organisms
What are citrate slants used for?

Citrate slants are used to determine the ability of an organisim to use citrate as its sole source of carbon. An organism producing citrase will convert these items into pyruvic acid and ammonia.
What kind of test is a citrate slant?
Differential Enzyme test
What pH indicator is used in citrate slants and what does it indicate?
pH indicator: Bromthymol blue
Blue color = positive for citrase
Green color = negative for citrase